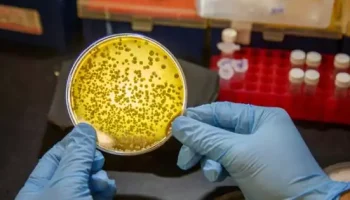

Scientists at Nanyang Technological University, Singapore (NTU Singapore) have surmounted a major technological obstacle in developing new sulphur-based medications, opening the door to the development
Researchers created a microbial encapsulation technique for therapeutic bacteria that can conceal them from immune systems, allowing them to access tumors more effectively and destroy cancer cells in mice. Columbia